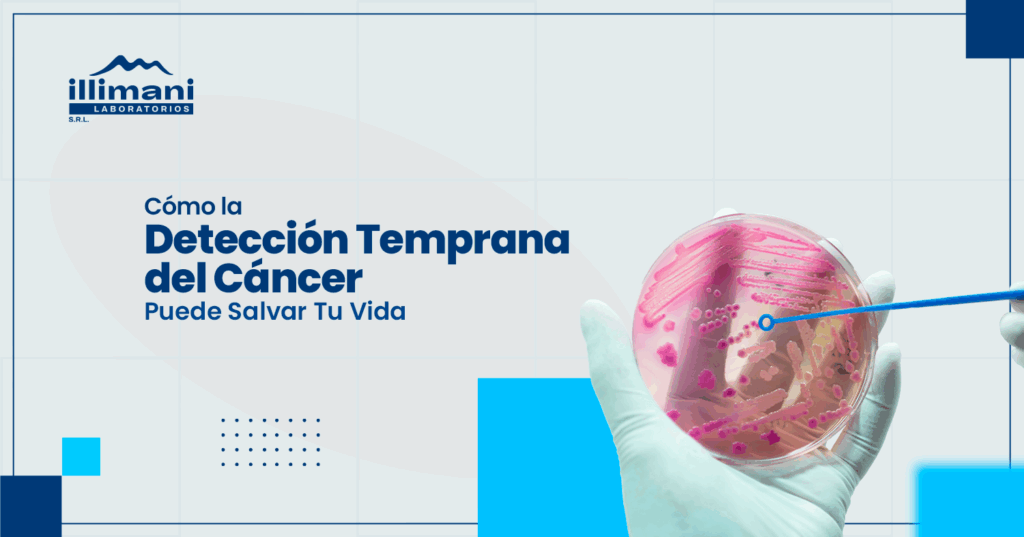

¿Cómo saber si tienes problemas en los riñones? Pruebas para detectarlo a tiempo

Los riñones cumplen funciones vitales como filtrar toxinas y regular el equilibrio de líquidos en el cuerpo. Sin embargo, muchas enfermedades renales no presentan síntomas en etapas iniciales, por lo que los análisis clínicos son esenciales para detectarlas temprano y evitar complicaciones graves como insuficiencia renal. Función renal y su importancia Los riñones eliminan desechos, […]
¿Qué es un hemograma y qué revela sobre tu salud?

El hemograma es uno de los análisis más comunes y útiles en medicina. Se trata de un examen de sangre que brinda información detallada sobre los componentes celulares de la sangre, como glóbulos rojos, glóbulos blancos y plaquetas. Este examen es clave para detectar diversas condiciones de salud, desde infecciones hasta anemia o trastornos de […]
Salud femenina: exámenes de laboratorio recomendados para mujeres

La salud femenina requiere atención especial en todas las etapas de la vida. Los exámenes de laboratorio son herramientas fundamentales para detectar a tiempo problemas comunes como anemia, alteraciones hormonales o infecciones, y así mantener un bienestar integral. Conocer cuáles análisis realizar y cuándo hacerlo es clave para un cuidado efectivo. Exámenes básicos recomendados para […]
Salud del corazón: análisis clave para prevenir enfermedades cardiovasculares

La salud del corazón es fundamental para una vida larga y activa. Las enfermedades cardiovasculares son una de las principales causas de muerte a nivel mundial, pero muchas pueden prevenirse con hábitos saludables y un control adecuado. Los análisis clínicos juegan un papel crucial para identificar factores de riesgo, como el colesterol alto y los […]
El Papel de los Análisis de Sangre en la Detección de Enfermedades Silenciosas

Los análisis de sangre son una de las herramientas más importantes en el diagnóstico médico. Aunque muchos pueden considerarlos solo como una prueba rutinaria, los análisis de sangre tienen un papel crucial en la detección temprana de enfermedades silenciosas. Estas son aquellas afecciones que no presentan síntomas evidentes en sus primeras etapas, lo que las […]
El Hemograma Completo: Una Evaluación Integral de Tu Salud

El hemograma completo es una prueba fundamental que ofrece una visión integral de tu salud general. Analiza diferentes componentes de la sangre para detectar problemas de salud, desde anemia hasta infecciones. Componentes del Hemograma Completo: ¿Cuándo Realizar Esta Prueba? Conclusión: El hemograma completo es una herramienta esencial para evaluar tu salud general y detectar problemas […]
Cómo la Detección Temprana del Cáncer Puede Salvar Tu Vida: Pruebas de Laboratorio Esenciales
El cáncer es una de las principales causas de muerte en todo el mundo, pero con la detección temprana, las posibilidades de tratamiento exitoso y recuperación aumentan considerablemente. En este artículo, exploraremos las pruebas de laboratorio esenciales para la detección temprana del cáncer y cómo estas pueden marcar la diferencia entre la vida y la […]
La Importancia del Chequeo Anual: ¿Qué Pruebas de Laboratorio Necesitas Realizarte?

El cuidado de la salud no debe limitarse a la visita al médico solo cuando te sientes mal. Los chequeos anuales son fundamentales para monitorear tu salud, prevenir enfermedades y detectar cualquier problema en sus etapas iniciales, cuando son más fáciles de tratar. Este artículo explorará las pruebas de laboratorio esenciales que deberías considerar en […]
Exámenes de Laboratorio para la Salud Femenina: Lo Que Toda Mujer Debe Saber

La salud femenina requiere un enfoque especializado, y los exámenes de laboratorio juegan un papel crucial en el diagnóstico y prevención de diversas enfermedades a lo largo de la vida de una mujer. Este artículo te guiará a través de los exámenes más importantes que toda mujer debería considerar. Exámenes Recomendados Según la Etapa de […]

